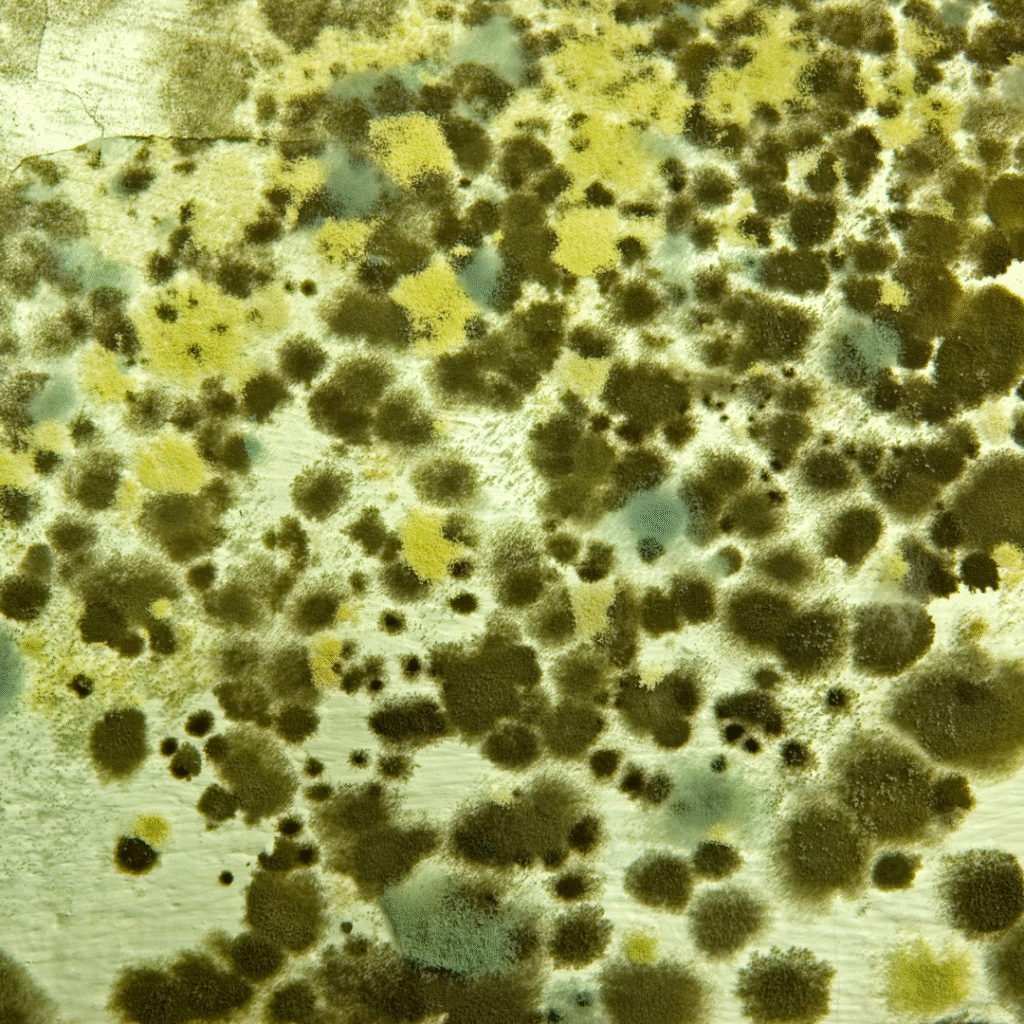

Mold is one of those household issues that often goes unnoticed—until it starts affecting how you feel. From unexplained allergies to lingering fatigue, mold exposure can quietly impact indoor air quality and overall health.
Understanding the different types of mold, how they can affect the body, and what steps to take can help you make informed decisions about your living space and your health.
Common Types of Mold Found in Homes
Not all mold is the same. Some types are relatively harmless, while others can be more concerning—especially with prolonged exposure.
1. Cladosporium
- Often found on wood, fabrics, carpets, and HVAC systems
- Can grow in cooler areas, including indoors
- May trigger allergy-like symptoms such as sneezing, coughing, or watery eyes
2. Aspergillus
- Common in dust, walls, insulation, and air conditioning systems
- Some species produce mycotoxins
- Can affect respiratory health, especially for those with asthma or compromised immune systems
3. Penicillium
- Frequently found on water-damaged materials
- Spreads quickly through spores
- May contribute to sinus infections, asthma flare-ups, and chronic inflammation
4. Stachybotrys (Black Mold)
- Grows on materials with long-term moisture exposure
- Produces mycotoxins
- Can be associated with more severe symptoms when exposure is prolonged
5. Alternaria
- Often found in damp areas like bathrooms and basements
- Common allergen that may worsen asthma and seasonal allergy symptoms

How Mold Can Impact Health
Mold exposure affects people differently. While some may experience mild symptoms, others—especially children, older adults, or those with chronic conditions—may be more sensitive.
Potential health effects include:
- Chronic nasal congestion or sinus issues
- Persistent coughing or throat irritation
- Headaches or brain fog
- Fatigue or low energy
- Skin irritation
- Worsening asthma or allergy symptoms
Because symptoms can be vague or overlap with other conditions, mold exposure often goes unrecognized as the underlying cause.
What to Do If You Suspect Mold in Your Home
1. Don’t Ignore Moisture
Leaks, condensation, flooding, or high humidity create ideal conditions for mold growth. Addressing moisture is always the first step.
2. Avoid Guesswork
Visible mold is only part of the picture. Mold can grow behind walls, under flooring, or in HVAC systems where it’s not immediately obvious.
3. Consider Professional Guidance
Understanding what type of mold is present—and at what levels—can help guide appropriate next steps without unnecessary remediation.
4. Test Before You Treat
Testing provides clarity. It helps identify whether mold is present, what type it is, and how widespread the issue may be.
How Healthy Spaces Consulting Can Help
Bridget at Healthy Spaces Consulting specializes in helping homeowners and renters understand their indoor environments—without panic or pressure.
Whether you’re dealing with unexplained health symptoms, a musty smell, or a history of water damage, Bridget can help you determine the best path forward.
Your options include:
- Scheduling a personalized consultation to review concerns and results
- Purchasing mold test kits to assess your home with expert interpretation and guidance
Testing and consultation allow you to take action based on facts—not fear.
Take the Next Step Toward a Healthier Home
You don’t need to guess whether mold is affecting your space or your health.
Visit this page to learn more, schedule a consultation and/or purchase a mold test kit and take the first step toward a healthier indoor environment.
Bridget is incredible. We used her to help us find and treat mold in our home. She is willing to travel, was available quickly and performed a thorough investigation. She provided an incredibly detailed report that also included other home health recommendations. She did not cause us any panic or fear and treated the situation logically and practically. And it worked! Our home is mold free, and we have Bridget’s recommendations in place to keep it that way. I highly recommend Bridget for any home health needs.
Sally H., homeowner
